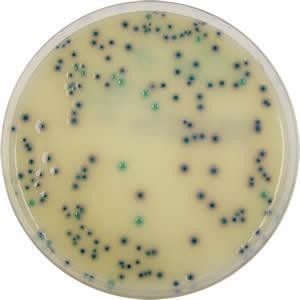
Discuri antibiograma

Discuri antibiograma
Pret: 7.50 lei + TVA / cart. x 50 disc
Produs publicat de: BIOMETRIA MEDICAL SERVICES -- Bucuresti (Bucuresti) , telefon: 0723 630 948 / 0723 630 948
Produs publicat de: BIOMETRIA MEDICAL SERVICES -- Bucuresti (Bucuresti) , telefon: 0723 630 948 / 0723 630 948
NR CRT
NR CRTDENUMIRE PRODUS
AMBALARE
PRET LEI FARA TVA
1
Amikacin 30
Cartus x 50comp
7.50
2
Acid fusidic 10
Cartus x 50comp
7.50
3
Acid Nalidixic 35
Cartus x 50comp
7.50
4
Amoxicillin 10
Cartus x 50comp
7.50
5
Amoxicilin 25
Cartus x 50comp
7.50
6
Ampicillin 10
Cartus x 50comp
7.50
7
Ampicilin 25
Cartus x 50comp
7.50
8
Ampicilina/Sulbactam
Cartus x 50comp
7.50
9
Amoxiclav 20/10 30 mg
Cartus x 50comp
7.50
10
Amphotericin B
Cartus x 50comp
7.50
11
Augmentin 20/10
Cartus x 50comp
7.50
12
Azitromicin 5
Cartus x 50comp
7.50
13
Azithromicin 15
Cartus x 50comp
7.50
15
Aztreonam 30
Cartus x 50comp
7.50
16
Bacitracin 5
Cartus x 50comp
7.50
17
Bacitracin 10
Cartus x 50comp
7.50
18
Biseptol
Cartus x 50comp
7.50
19
Carbenicillin 100
Cartus x 50comp
7.50
20
Ceftazidime 30
Cartus x 50comp
7.50
21
Ceftazidime/Clavulan 30/10
Cartus x 50comp
7.50
22
Cefoperazone 75
Cartus x 50comp
7.50
23
Cefotaxime/clavulan
Cartus x 50comp
7.50
24
Cefoperazone /Sulbactam
Cartus x 50comp
7.50
25
Cephalothin 30
Cartus x 50comp
7.50
26
Cephazoline 30
Cartus x 50comp
7.50
27
Cefamandole 30
Cartus x 50comp
7.50
28
Cefaclor 30
Cartus x 50comp
7.50
29
Cefepime 30
Cartus x 50comp
7.50
30
Cefoxitin 30
Cartus x 50comp
7.50
31
Cefixime
Cartus x 50comp
7.50
32
Cephalexin 30
Cartus x 50comp
7.50
33
Cefotaxime 30
Cartus x 50comp
7.50
34
Ceftibuten
Cartus x 50comp
7.50
35
Ceftriaxone 30
Cartus x 50comp
7.50
36
Cefuroxime 30
Cartus x 50comp
7.50
37
Cexil
Cartus x 50comp
7.50
38
Ciprofloxacin
Cartus x 50comp
7.50
39
Chloramphenicol 30
Cartus x 50comp
7.50
40
Clarytromicin 15
Cartus x 50comp
7.50
41
Clindamycin 2
Cartus x 50comp
7.50
42
Clotrimazole
Cartus x 50comp
7.50
43
CoTrimoxazole 25
Cartus x 50comp
7.50
44
Colistin sulfat 10
Cartus x 50comp
7.50
45
Doxicicline 30
Cartus x 50comp
7.50
46
Econazole
Cartus x 50comp
7.50
47
Enrofloxacin 5
Cartus x 50comp
7.50
48
Erythromycin 15
Cartus x 50comp
7.50
49
Erpapenem 10
Cartus x 50comp
7.50
50
Fosfomicin
Cartus x 50comp
7.50
51
Fluconazole
Cartus x 50comp
7.50
52
Furazolidon
Cartus x 50comp
7.50
53
Gentamicin 10
Cartus x 50comp
7.50
54
Gentamicin 120
Cartus x 50comp
7.50
55
Imipenem 10
Cartus x 50comp
7.50
56
Itraconazole
Cartus x 50comp
7.50
57
Kanamycin 30
Cartus x 50comp
7.50
58
Ketoconazole
Cartus x 50comp
7.50
59
Levofloxacin
Cartus x 50comp
7.50
60
Lincomicin 15
Cartus x 50comp
7.50
61
Linezolid
Cartus x 50comp
7.50
62
Meropenem 10
Cartus x 50comp
7.50
63
Meticillin 5
Cartus x 50comp
7.50
64
Mupirocin 5
Cartus x 50comp
7.50
65
Mecilinam
Cartus x 50comp
7.50
66
Natamycin 30
Cartus x 50comp
7.50
67
Neomicin 10
Cartus x 50comp
7.50
68
Neomicin 30
Cartus x 50comp
7.50
69
Nitrofurantoin 300
Cartus x 50comp
7.50
70
Netilmicin 30
Cartus x 50comp
7.50
71
Norfloxacin 10
Cartus x 50comp
7.50
72
Novobiocin 5
Cartus x 50comp
7.50
73
Novobiocin 30
Cartus x 50comp
7.50
74
Nystatin 100
Cartus x 50comp
7.50
75
Ofloxacin 5
Cartus x 50comp
7.50
76
Optochin 10
Cartus x 50comp
7.50
77
Oxacilin 1
Cartus x 50comp
7.50
78
Oxacillin 5
Cartus x 50comp
7.50
79
Penicillin G 10
Cartus x 50comp
7.50
80
Perfloxacin 5
Cartus x 50comp
7.50
81
Piperacillin 100
Cartus x 50comp
7.50
82
Piperacilin Tazobactam 100/10
Cartus x 50comp
7.50
83
Polimixin B 300
Cartus x 50comp
7.50
84
Rifampcin 5
Cartus x 50comp
7.50
85
Streptomycin 300
Cartus x 50comp
7.50
86
Sulperazone
Cartus x 50comp
7.50
87
Teicoplanin 30
Cartus x 50comp
7.50
88
Tetracicline 30
Cartus x 50comp
7.50
89
Ticarcillin 75
Cartus x 50comp
7.50
90
Ticarcillin /clavulanic acid
Cartus x 50comp
7.50
91
Tobramicin 10
Cartus x 50comp
7.50
92
Trimetroprim sulfonazole
Cartus x 50comp
7.50
93
Trimethoprim 5
Cartus x 50comp
7.50
Solicitare informații / comandă produs (mesaj către BIOMETRIA MEDICAL SERVICES):
Nr. vizite 4161
